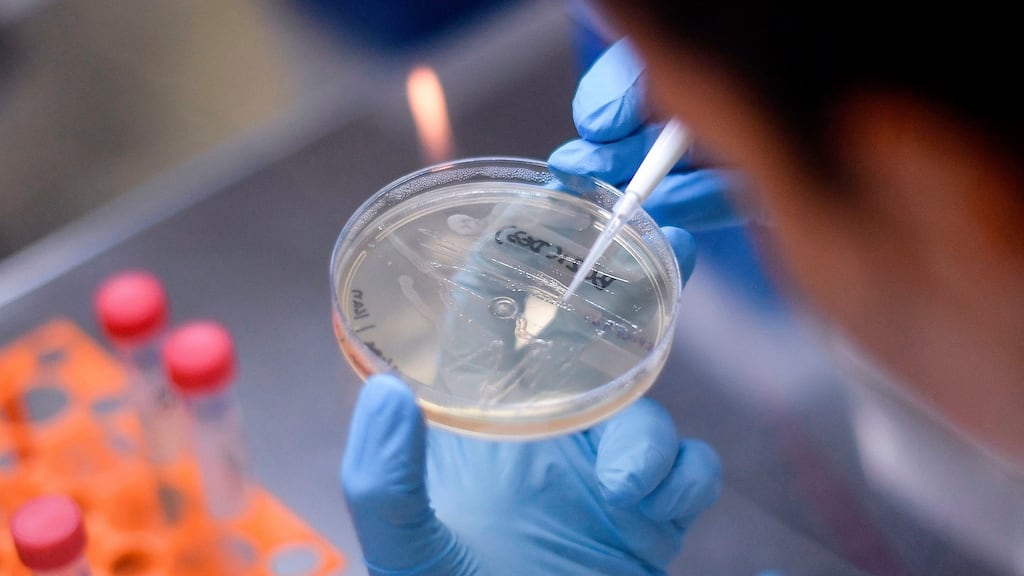
Academics warn there is no guarantee that a coronavirus vaccine will be developed. Photograph: Douglas Magno/AFP via Getty

Ireland is facing the “strong likelihood of an imminent second wave” of coronavirus, as the country reopened before eradicating the virus from the island, a group of leading academics has warned.
The group, which includes many high-profile public health experts and epidemiologists, set out how Ireland could move towards a "zero-Covid island", similar to New Zealand.
The wearing of face masks should be legally enforced in outdoor crowds and indoor public spaces. Restrictions should be reintroduced locally in areas with continued community transmission of the virus. Lockdown measures should be relaxed in “green zones” free of coronavirus cases, according to the group.
The zero-Covid island strategy follows a June 8th open letter by the scientists and researchers calling for the government to “crush” the virus on an all-island basis, before lifting lockdown measures.
There has been more than 100 additional coronavirus cases reported in the past five days, as the economy continues to reopen.
The group includes professor of public health Anthony Staines of DCU; infectious diseases ecologist Prof Gerard Killeen of UCC; immunologist Dr Tomás Ryan of TCD; Prof Patricia Kearney of UCC; Prof Gabriel Scally; and RCSI infectious diseases expert Prof Sam McConkey.
Travel regulations
The Government needed to ensure the “proper regulation of travel” and mandatory quarantine for people entering the country, “supplemented with repeated serial testing before release”, the group said.
Prof Killeen said this would mean replicating the “gold standard” approach of New Zealand. “They’ll take you to your isolation accommodation and make sure you stay there for two weeks, and test you several times before they let you go,” he told The Irish Times.
Dr Ryan said there was no single “magic bullet” measure, but the issue of foreign travel into the country had the potential “in itself to be catastrophic”.
The problem was also the “easiest to fix” with the introduction of mandatory quarantine for people arriving into Ireland, and frequent testing before they entered the wider community, he said.
The country was “now facing the strong likelihood of an imminent second wave”, the group said.
“Unless we take immediate and decisive action, we will pay a very heavy price, with many people getting sick, being admitted to ICU and dying,” the group said in a statement on Tuesday.
“Many businesses will fold, because a second wave will bring a second dip in activity, whether from Government policy, or customer fears, which will extend their losses well into 2021,” it said.
The aim of the strategy is to reduce the incidence of Covid-19 to zero on the island of Ireland, “so that we can safely open up as much of our society and economy as possible”, the group said.
The country could then set up “safe travel bridges” between other countries with similar “zero-Covid strategies”, it said.
The academics warned there was no guarantee that a coronavirus vaccine would be developed. Even if an effective drug was produced, “it may take a number of years to become widely available in sufficient quantities”, the group said.
“A zero-Covid island is our only viable exit strategy from the ongoing Covid-19 epidemic, which may otherwise last for years or indefinitely,” the group said.